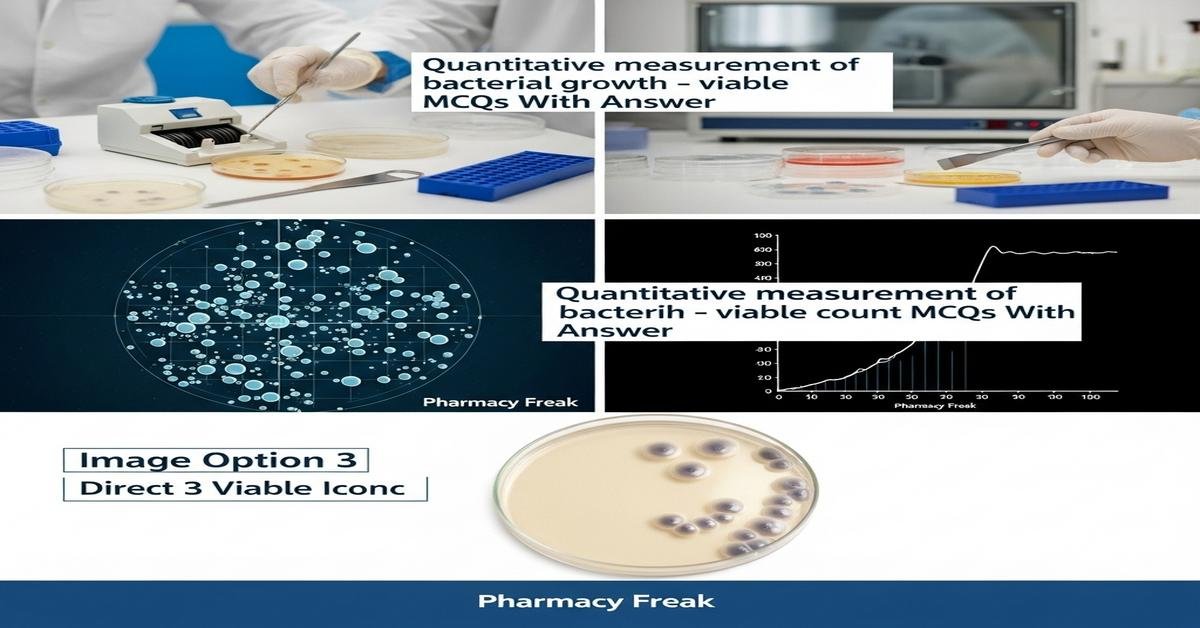
Quantitative measurement of bacterial growth – viable count MCQs With Answer

Quantitative measurement of bacterial growth – viable count MCQs With Answer
Quantitative measurement of bacterial growth is essential for B. Pharm students involved in microbiology, sterility testing, and quality control. Viable count methods such as plate count (spread and pour), membrane filtration, and Most Probable Number (MPN) quantify colony-forming units (CFU) to assess microbial load. Key concepts include serial dilution, detection limits, incubation conditions, selective media, viable but non-culturable cells, and statistical reliability of counts. Mastery of CFU calculations, plating techniques, and standards (USP/ISO) helps ensure accurate microbial assays in pharmaceutical practice. ‘Now let’s test your knowledge with 50 MCQs on this topic.’
Q1. What does CFU stand for in viable count methods?
- Colony Forming Unit
- Cell Formation Unit
- Catalytic Fungal Unit
- Culture Fouling Unit
Correct Answer: Colony Forming Unit
Q2. Which method directly measures only viable bacteria capable of forming colonies?
- Plate count method
- Optical density measurement
- DNA-based PCR assay
- Flow cytometry with total stain
Correct Answer: Plate count method
Q3. In serial dilution, what is the dilution factor when 1 mL is added to 9 mL of diluent?
- 1:10
- 1:9
- 1:100
- 9:10
Correct Answer: 1:10
Q4. Which plate count range is generally considered countable for accuracy?
- 30–300 colonies
- 1–30 colonies
- 300–1000 colonies
- Over 1000 colonies
Correct Answer: 30–300 colonies
Q5. In a spread plate technique, what volume is typically spread on the agar surface?
- 0.1 mL
- 1.0 mL
- 5.0 mL
- 10 mL
Correct Answer: 0.1 mL
Q6. Which technique is best for samples with very low bacterial counts (e.g., water testing)?
- Membrane filtration
- Spread plating 0.1 mL
- Hemocytometer counting
- Direct turbidity measurement
Correct Answer: Membrane filtration
Q7. The pour plate method differs from spread plate method because colonies:
- Form within and on the surface of the agar
- Only form on the surface
- Form only in broth culture
- Require anaerobic incubation
Correct Answer: Form within and on the surface of the agar
Q8. Which calculation converts plate colony count to CFU/mL for a plate with 120 colonies from 10^-4 dilution and 0.1 mL plated?
- 120 × 10^5 = 1.2 × 10^7 CFU/mL
- 120 × 10^4 = 1.2 × 10^6 CFU/mL
- 120 × 10^3 = 1.2 × 10^5 CFU/mL
- 120 ÷ 10^4 = 1.2 × 10^-2 CFU/mL
Correct Answer: 120 × 10^5 = 1.2 × 10^7 CFU/mL
Q9. Which factor does NOT directly affect colony formation on agar?
- Sample dilution accuracy
- Incubation temperature
- Light intensity in incubator
- Nutrient composition of medium
Correct Answer: Light intensity in incubator
Q10. What is the main limitation of optical density (OD) for bacterial quantification?
- It measures total cells including dead ones
- It requires selective media
- It is specific only to fungi
- It counts colonies manually
Correct Answer: It measures total cells including dead ones
Q11. Most Probable Number (MPN) estimates are useful for:
- Estimating low concentrations in liquid samples using statistical probability
- Direct colony counting on solid media
- Measuring optical density of cultures
- Counting spores on surfaces
Correct Answer: Estimating low concentrations in liquid samples using statistical probability
Q12. Which medium is often used for total aerobic plate counts in pharmaceutical QC?
- Plate Count Agar (PCA)
- MacConkey agar
- Potato dextrose agar
- Mannitol salt agar
Correct Answer: Plate Count Agar (PCA)
Q13. Why are serial dilutions necessary before plating dense bacterial cultures?
- To obtain countable colonies within the 30–300 range
- To sterilize the sample
- To increase nutrient concentration
- To change pH of the medium
Correct Answer: To obtain countable colonies within the 30–300 range
Q14. What does a “viable but non-culturable” (VBNC) state mean?
- Cells are alive but do not form colonies under standard conditions
- Cells are dead and fragmented
- Cells form colonies faster than normal
- Cells are resistant to antibiotics
Correct Answer: Cells are alive but do not form colonies under standard conditions
Q15. In pharmaceutical sterility testing, which regulation provides guidelines for microbial limits?
- USP and ISO standards
- FDA nutritional guidelines
- EPA air quality standards
- ICH Q10 only
Correct Answer: USP and ISO standards
Q16. When using a membrane filter, what pore size is commonly used to retain bacteria?
- 0.45 µm
- 5 µm
- 10 µm
- 50 µm
Correct Answer: 0.45 µm
Q17. Which unit is commonly reported for viable count results?
- CFU/mL or CFU/g
- Cells per mm^3
- Optical density units
- mg/L of biomass
Correct Answer: CFU/mL or CFU/g
Q18. Why is plating replicate dilutions recommended?
- To improve statistical reliability and identify outliers
- To consume more consumables
- To increase incubation time
- To reduce colony size
Correct Answer: To improve statistical reliability and identify outliers
Q19. What is the purpose of adding neutralizers during sampling for viable counts?
- To inactivate residual disinfectants that could kill microbes during testing
- To speed up colony growth
- To increase turbidity for OD readings
- To selectively enrich Gram-positive bacteria
Correct Answer: To inactivate residual disinfectants that could kill microbes during testing
Q20. In counting colonies on a plate, overlapping colonies cause which of the following problems?
- Underestimation of actual CFU
- Increased plating efficiency
- Accurate single-cell counts
- No effect on results
Correct Answer: Underestimation of actual CFU
Q21. Which statistical distribution is often used to model colony counts on plates?
- Poisson distribution
- Normal distribution only
- Uniform distribution
- Binomial distribution only
Correct Answer: Poisson distribution
Q22. A sample shows 45 colonies on a 10^-3 dilution plate where 0.1 mL was plated. What is the CFU/mL?
- 4.5 × 10^5 CFU/mL
- 4.5 × 10^4 CFU/mL
- 4.5 × 10^6 CFU/mL
- 4.5 × 10^3 CFU/mL
Correct Answer: 4.5 × 10^5 CFU/mL
Q23. Which technique reduces heat damage to heat-sensitive bacteria during plating?
- Spread plate on cooled agar
- Pour plate with molten agar
- Direct streak from hot loop
- Hot incubation at 60°C
Correct Answer: Spread plate on cooled agar
Q24. Which indicator is used to assess facultative anaerobes by redox change in some media?
- Resazurin
- Crystal violet
- Phenol red only
- Lugol’s iodine
Correct Answer: Resazurin
Q25. What is plating efficiency?
- The fraction of viable cells that form colonies under given conditions
- The percentage of medium solidified properly
- Time taken for colonies to appear
- Volume of agar poured per plate
Correct Answer: The fraction of viable cells that form colonies under given conditions
Q26. Which practice helps minimize counting errors when colonies are numerous?
- Choose a higher dilution with colonies in the countable range
- Use the plate with the most colonies regardless of range
- Always use 10^-1 dilution plates
- Ignore plates with less than 10 colonies
Correct Answer: Choose a higher dilution with colonies in the countable range
Q27. Why is agar depth important in pour plate method?
- Affects oxygen diffusion and colony distribution
- Changes the pH of the medium drastically
- Prevents agar from solidifying
- Increases the color of colonies
Correct Answer: Affects oxygen diffusion and colony distribution
Q28. When performing serial dilutions, which pipetting practice improves accuracy?
- Use calibrated pipettes and proper technique
- Blow out the last drop of pipette every time
- Use uncalibrated disposable pipettes only
- Change diluent for each dilution step
Correct Answer: Use calibrated pipettes and proper technique
Q29. Which contamination control is essential when preparing serial dilutions?
- Flame or sterile technique to avoid cross-contamination
- Leave caps off tubes throughout process
- Use hand towels to wipe pipettes
- Reuse the same pipette tip for all steps
Correct Answer: Flame or sterile technique to avoid cross-contamination
Q30. Which of the following describes the detection limit of a plating method?
- The lowest number of organisms that can be reliably detected per sample volume
- The maximum number of colonies that can grow on a plate
- The time required for colonies to be visible
- The smallest colony diameter measurable
Correct Answer: The lowest number of organisms that can be reliably detected per sample volume
Q31. What is the effect of prolonged incubation beyond recommended time on plate counts?
- Possible colony overgrowth and merging leading to undercounting
- Always yields more accurate counts
- Reduces colony size but increases number
- Sterilizes the plate
Correct Answer: Possible colony overgrowth and merging leading to undercounting
Q32. Which control plate should be included to ensure media sterility?
- Uninoculated media incubated as a control
- Plate with highest dilution only
- Plate incubated at 4°C
- Plate with excess antibiotic
Correct Answer: Uninoculated media incubated as a control
Q33. In pharmaceutical microbiology, what is the significance of USP <61> and <62>?
- Microbial enumeration and antimicrobial effectiveness tests guidance
- Guidelines for chemical assay only
- Guidelines for packaging materials
- Instructions for spectroscopy methods
Correct Answer: Microbial enumeration and antimicrobial effectiveness tests guidance
Q34. Which method helps differentiate between live and dead cells without culturing?
- Live/dead staining combined with fluorescence microscopy
- Standard plate count
- Pour plate with selective media
- Gram staining alone
Correct Answer: Live/dead staining combined with fluorescence microscopy
Q35. How does sodium thiosulfate help during sampling of disinfected surfaces?
- Neutralizes residual chlorine-based disinfectants
- Enhances disinfectant activity
- Acts as a nutrient for bacteria
- Prevents colony formation on agar
Correct Answer: Neutralizes residual chlorine-based disinfectants
Q36. Which plating volume is often used in membrane filtration to deliver sample onto filter?
- Variable volumes (e.g., 10–100 mL) depending on sample
- Always 0.1 mL
- Exactly 1 mL only
- Only 0.01 mL
Correct Answer: Variable volumes (e.g., 10–100 mL) depending on sample
Q37. What does a high plating efficiency indicate?
- Most viable cells in the sample are capable of forming colonies under test conditions
- Media is contaminated
- All cells are dead
- Pipetting errors occurred
Correct Answer: Most viable cells in the sample are capable of forming colonies under test conditions
Q38. Which approach is used to count anaerobic bacteria accurately?
- Use anaerobic jars or chambers and appropriate media
- Incubate plates in the open air
- Use high-oxygen shaking incubators
- Perform only optical density measurements
Correct Answer: Use anaerobic jars or chambers and appropriate media
Q39. If two plates from the same dilution give counts of 60 and 72, how should the result be reported?
- Average of both counts used for CFU calculation
- Discard both plates and use next dilution only
- Report only the higher count
- Report only the lower count
Correct Answer: Average of both counts used for CFU calculation
Q40. What is the role of selective media in viable counts?
- Allow growth of target organisms while inhibiting others
- Increase total microbial diversity on plate
- Enhance turbidity measurements
- Prevent any bacterial growth
Correct Answer: Allow growth of target organisms while inhibiting others
Q41. How can viable counts be biased by clumping of cells?
- Clumps form single colonies causing underestimation of CFU
- Clumping increases CFU proportionally
- Clumping has no effect on counts
- Clumping always kills the cells
Correct Answer: Clumps form single colonies causing underestimation of CFU
Q42. Which step reduces the effect of antimicrobial residues on viable count results?
- Use of neutralizers in diluents and recovery media
- Use higher incubation temperatures
- Omit dilution steps
- Filter sterilize the sample completely
Correct Answer: Use of neutralizers in diluents and recovery media
Q43. Automated colony counters primarily help to:
- Reduce manual counting errors and speed throughput
- Replace the need for serial dilutions
- Eliminate incubation time
- Detect VBNC cells directly
Correct Answer: Reduce manual counting errors and speed throughput
Q44. What is the primary reason to incubate plates at specified temperatures?
- To support optimal growth rate of target organisms
- To sterilize the media
- To evaporate excess moisture
- To induce sporulation only
Correct Answer: To support optimal growth rate of target organisms
Q45. When plating an environmental swab, what is a common practice to transfer organisms to media?
- Vortex the swab in neutralizing buffer then plate aliquots
- Dry the swab and press directly on agar without buffer
- Incinerate the swab before plating
- Freeze the swab and then plate frozen
Correct Answer: Vortex the swab in neutralizing buffer then plate aliquots
Q46. Which error leads to systematic underestimation of CFU/mL?
- Poor mixing during serial dilution
- Using proper sterile technique
- Plating correct dilution volume
- Selecting plates within 30–300 colony range
Correct Answer: Poor mixing during serial dilution
Q47. For spore counts, why might a heat-shock step be applied before plating?
- To kill vegetative cells and select for heat-resistant spores
- To sterilize the sample completely
- To reduce spore formation
- To increase vegetative cell counts
Correct Answer: To kill vegetative cells and select for heat-resistant spores
Q48. Which factor must be recorded along with plate counts for proper documentation?
- Dilution factor, plated volume, incubation conditions, and plate count
- Only the technician name
- Only the color of colonies
- Only the type of incubator used
Correct Answer: Dilution factor, plated volume, incubation conditions, and plate count
Q49. In comparing spread plate to pour plate, which statement is true?
- Spread plates give colonies only on the surface and are better for oxygen-requiring organisms
- Pour plates always give more accurate counts for aerobes on the surface
- Spread plates require molten agar to be mixed with sample
- Pour plates prevent anaerobe growth entirely
Correct Answer: Spread plates give colonies only on the surface and are better for oxygen-requiring organisms
Q50. Which practice improves recovery of stressed or injured bacteria during viable counts?
- Use of non-selective recovery media and longer incubation at appropriate temperature
- Using highly selective media only
- Incubate at extreme temperatures to speed growth
- Omit dilutions to maximize colony numbers
Correct Answer: Use of non-selective recovery media and longer incubation at appropriate temperature

I am a Registered Pharmacist under the Pharmacy Act, 1948, and the founder of PharmacyFreak.com. I hold a Bachelor of Pharmacy degree from Rungta College of Pharmaceutical Science and Research. With a strong academic foundation and practical knowledge, I am committed to providing accurate, easy-to-understand content to support pharmacy students and professionals. My aim is to make complex pharmaceutical concepts accessible and useful for real-world application.
Mail- Sachin@pharmacyfreak.com